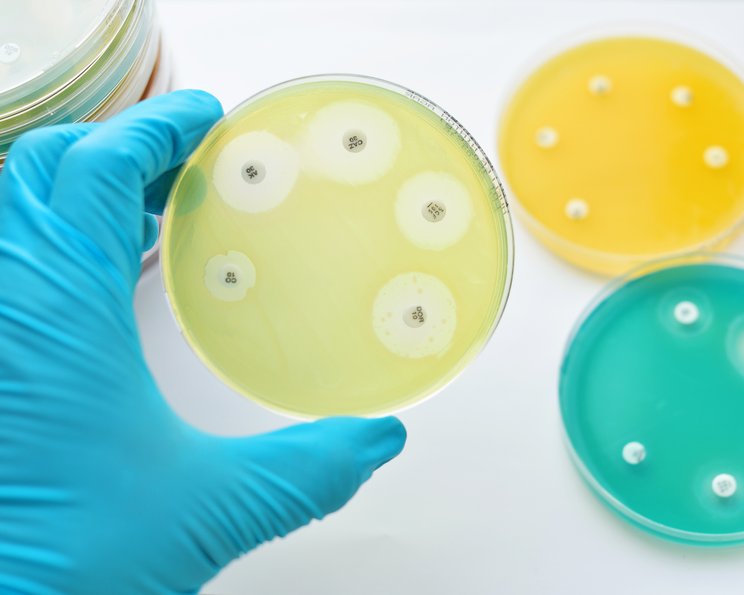
ORSA (Oxacillin-resistenter Staphylococcus aureus)

ORSA (Oxacillin-resistenter Staphylococcus aureus)
Der Erreger Staphylococcus aureus kann gegen unterschiedliche Antibiotika resistent werden. Dies betrifft vor allem die Antibiotikagruppe der Penicilline. Dazu gehört u.a. der Wirkstoff Oxacillin.
Erregerstämme, die gegen Oxacillin unempfindlich reagieren, werden als Oxacillin-resistenter Staphylococcus aureus oder ORSA bezeichnet. Die Abkürzung ORSA wird parallel zu MRSA (Methicilin-resistenter Staphylococcus Aureus) verwendet. Beide Gruppen gehören zu den multiresistenten Keimen bzw. multiresistenten Erregern (MRE).


